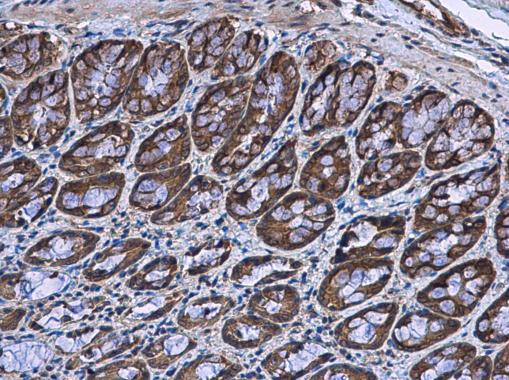
BBS4 Antibody in Immunohistochemistry (Paraffin) (IHC (P))

Search
Invitrogen
BBS4 Polyclonal Antibody
{{$productOrderCtrl.translations['antibody.pdp.commerceCard.promotion.promotions']}}
{{$productOrderCtrl.translations['antibody.pdp.commerceCard.promotion.viewpromo']}}
{{$productOrderCtrl.translations['antibody.pdp.commerceCard.promotion.promocode']}}: {{promo.promoCode}} {{promo.promoTitle}} {{promo.promoDescription}}. {{$productOrderCtrl.translations['antibody.pdp.commerceCard.promotion.learnmore']}}
图: 1 / 2
BBS4 Antibody (PA5-78617) in IHC (P)


产品信息
PA5-78617
种属反应
宿主/亚型
分类
类型
抗原
偶联物
形式
浓度
规格
纯化类型
保存液
内含物
保存条件
运输条件
RRID
产品详细信息
Positive Control: Neuro2A, C8D30, NIH-3T3, rat colon
Predicted Reactivity: Human (100%), Pig (92%), Chimpanzee (98%), Bovine (91%)
Store product as a concentrated solution. Centrifuge briefly prior to opening the vial.
靶标信息
BBS4 contains tetratricopeptide repeats (TPR), similar to O-linked N-acetyglucosamine transferase. Mutations in the gene encoding this protein have been observed in patients with Bardet-Biedl syndrome type 4. BBS4 may play a role in pigmentary retinopathy, obesity, polydactyly, renal malformation and mental retardation.
仅用于科研。不用于诊断过程。未经明确授权不得转售。
篇参考文献 (0)
生物信息学
蛋白别名: Bardet-Biedl syndrome 4 homolog; Bardet-Biedl syndrome 4 protein; Bardet-Biedl syndrome 4 protein homolog; BBS4; BBSome complex member BBS4; unnamed protein product
基因别名: AW537059; AW742241; BBS4; D9Ertd464e
UniProt ID: (Human) Q96RK4, (Mouse) Q8C1Z7
Entrez Gene ID: (Human) 585, (Mouse) 102774, (Rat) 300754